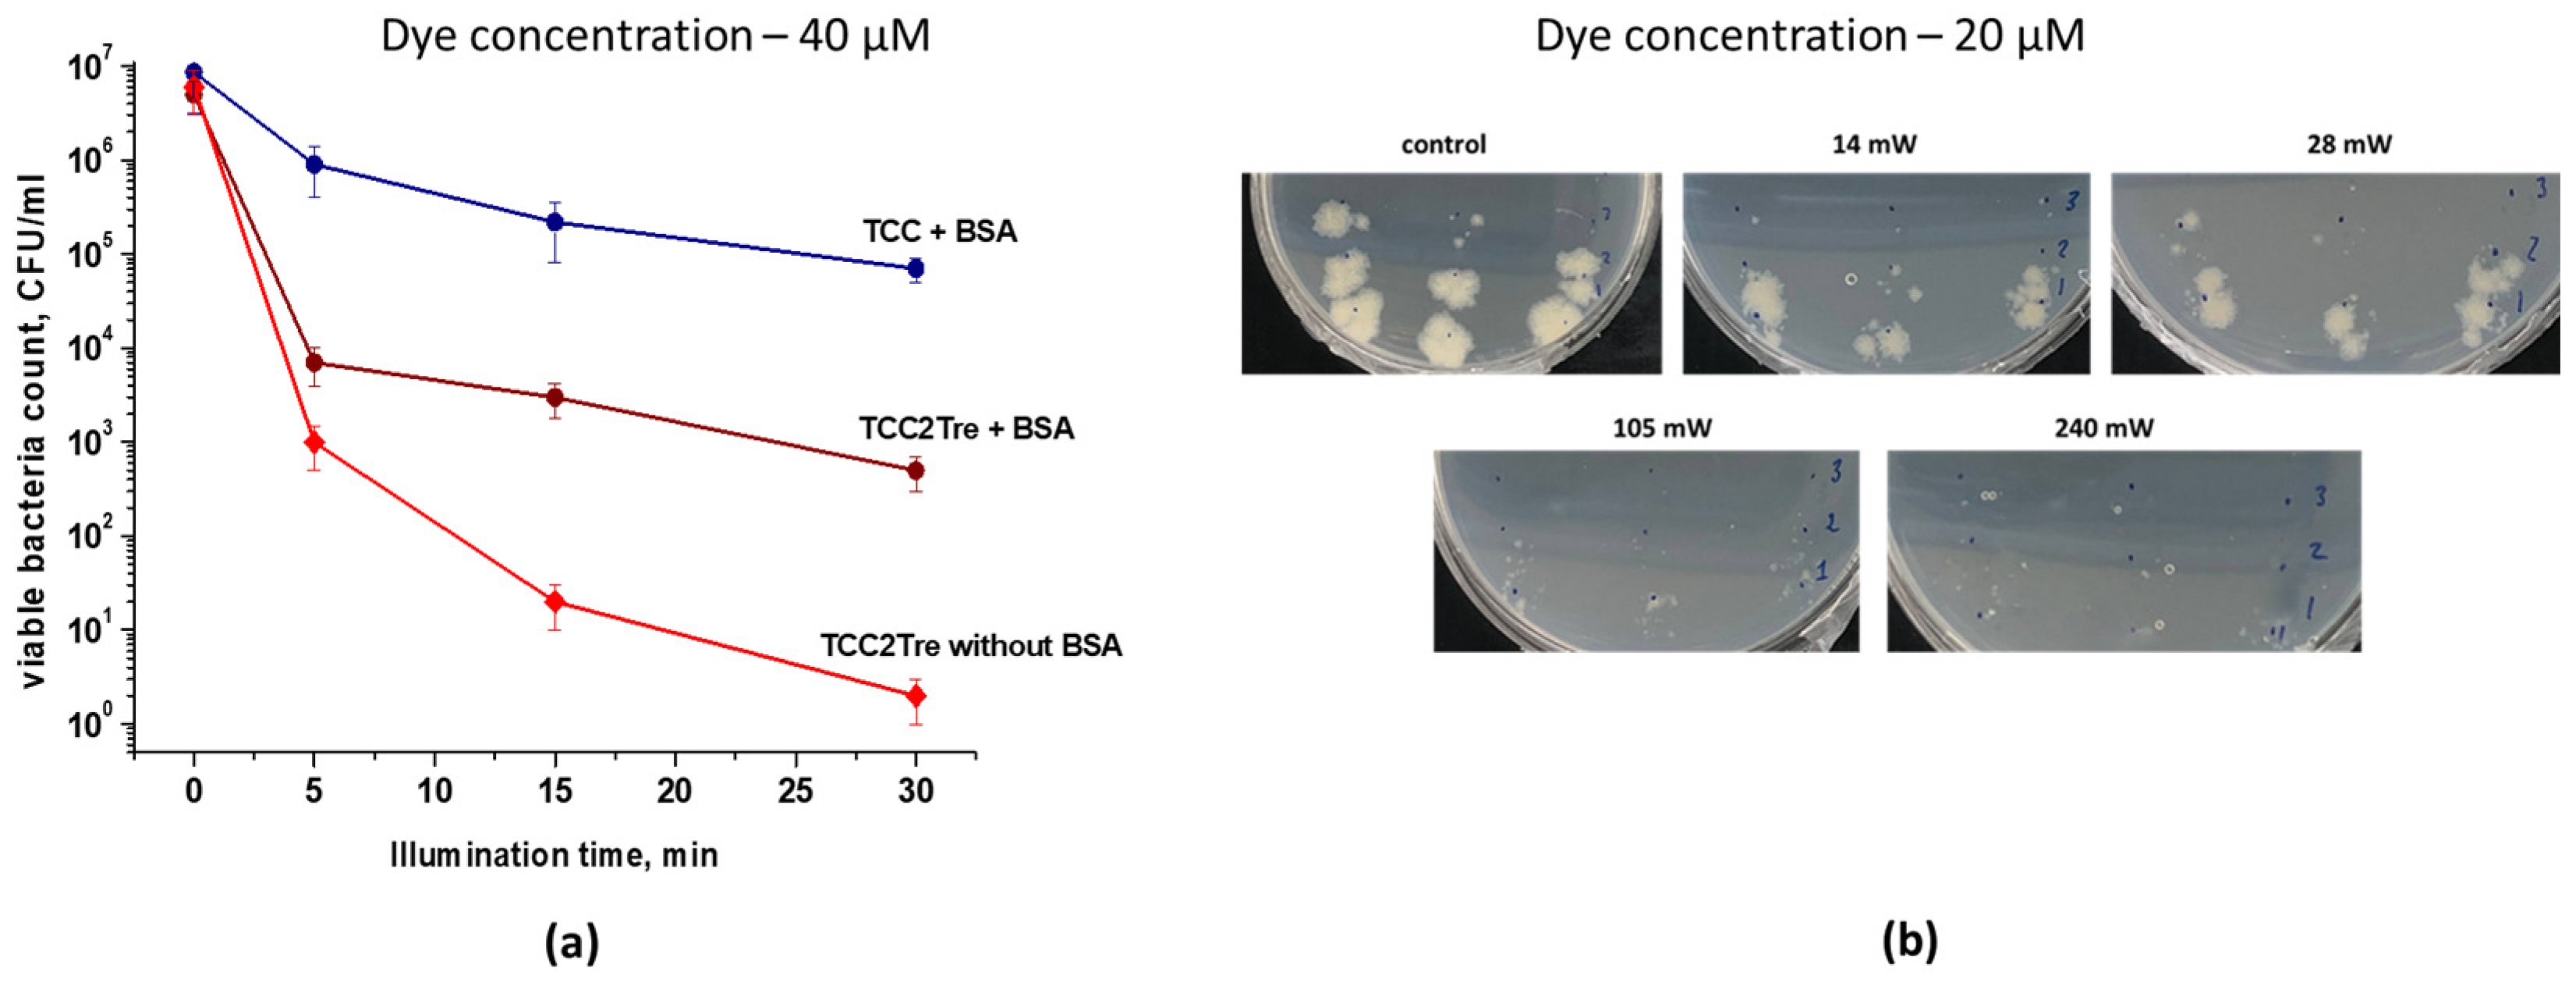
Ijms 25 08505 g010

1. Introduction
Most pathogenic mycobacteria cause lung infections, although in some cases lymph nodes, bones and joints, skin and wounds are affected [
1]. However, the most concerning disease caused by mycobacteria is tuberculosis (TB), caused by
Mycobacterium tuberculosis. The situation with this disease is complicated by the high and increasing levels of antibiotic-resistant strains of
M. tuberculosis and multidrug-resistant tuberculosis resistant to first-line antibiotics (isoniazid and rifampicin). Chemotherapy treatment for such infections has extremely limited effectiveness [
2].
A special aspect of this problem is the ability of pathogenic mycobacteria to form dormant forms to survive under stress conditions, including in the host body. In this state, bacteria stop all biosynthetic processes, including those that are targeted by antibiotics, and thus become invulnerable to the action of antimicrobial drugs.
M. tuberculosis in a dormant state is the cause of latent tuberculosis—a widespread, asymptomatic, and difficult-to-treat form [
3]. Such forms of mycobacteria are able to remain viable for a long time in the human body before entering an active state, causing the resumption of the disease, for example, in the treatment of coronavirus inflammation using corticosteroids [
4].
The traditional direction for combating drug resistance is associated with the search for new antibiotic substances. Modern methods of identifying new targets in pathogen cells, deciphering their structures and selecting active substances using screening systems have significantly increased the efficiency of such studies. However, within a very short period of time from the start of using a new antibiotic in the clinic, resistant strains arise. Such cycles of developing new drugs and the subsequent emergence of resistant strains can be repeated indefinitely.
The combination of these challenges necessitates the development of fundamentally novel approaches to combat genetically determined resistant strains and dormant forms of mycobacteria.
Antimicrobial photodynamic therapy (aPDT), or photodynamic inactivation (PDI), represents an interesting alternative or adjunct to chemotherapy for microbiological control [
5]. This method reduces systemic toxicity, is non-invasive, minimizes antibiotic use and mitigates the risk of resistance due to its broad action on biomolecules. aPDT is a promising method for addressing various bacterial infections, particularly those that are antibiotic-resistant [
6]. Currently, methylene blue, radachlorin and various porphyrin derivatives are used as exogenous photosensitizers (PSs) for the inactivation of mycobacteria [
5]. Mycobacterial cells with endogenous accumulated porphyrines also exhibit a great sensitivity to illumination [
7,
8,
9]. Such PSs are activated by light with a wavelength not exceeding 690 nm, which prevents their widespread use for inactivating the pathogen in the deep tissues of the macroorganism. While the application of aPDT is not as widespread for mycobacteria as for other bacterial species, studies have shown that it can effectively deactivate various mycobacterial strains, especially those that cause skin infections, in both laboratory settings and animal models [
5]. Despite the fact that the inclusion of exogenous PS leads to a high inactivation effect in vitro, the use of chemically synthesized PSs is complicated by their transportation to localized foci of bacterial infections. This obviously limits the use of PDI to superficial (skin) diseases.
Consequently, a promising avenue of research is the application of new PSs activated in the near-infrared range to kill mycobacteria, which should increase the depth of the effective action of light. The rationale for this assumption is the use of tricarbocyanine (TCC) dyes activated in the near-infrared range (780 nm), which has been demonstrated to increase the depth of tumor damage [
10]. However, until now, such PSs have not been used for the PDI of mycobacteria.
The second challenge when using exogenous PSs to inactivate mycobacteria located inside the host body is the potential for side effects on host tissues. When conducting aPDT using hydroxyaluminum phthalocyanine (Photosens) as a PS in an experimental model of tuberculosis infection in mice, it was demonstrated that the tissues of the experimental animal retained a significant amount of light energy. Nevertheless, the residual light transmission was sufficient to provide a pronounced therapeutic effect, manifested in a significant reduction of the mycobacterial load and specific inflammatory process in all examined internal organs [
11]. However, side effects on the host organism were observed when using light with a high dose density (above 100 J/cm
2). While it effectively inactivates
M. tuberculosis, this illumination regimen is unacceptable for clinical purposes, as it causes severe photonecrosis of photosensitized tissues [
12].
To enhance the specificity of PSs targeting bacteria, the conjugation of fluorescent molecules with antibiotics, peptides and antibodies was employed [
13]. In particular, trehalose-related PSs for the PDI of mycobacteria were synthesized and studied [
14,
15].
Trehalose is an essential component for mycobacteria [
16] and serves as a precursor for various glycolipids in their cell envelopes [
17]. Mycobacteria are capable of producing trehalose internally but can also use trehalose from external sources. Indeed, mycobacteria have an effective trehalose transporter, which is localized in the cell wall. This transporter can transport trehalose and trehalose analogues, including conjugates with PSs, from the external environment into the bacterium [
15,
18]. Because trehalose is not produced by mammals, the basis for selectivity of trehalose-linked PS uptake by bacterial cells within a macroorganism is established [
18]. It was shown that
14C-trehalose can effectively enter and be absorbed by mouse macrophages and is subsequently taken up by
M. tuberculosis bacteria within those cells [
19]. This result illustrates the potential of trehalose-functionalized probes for in vivo applications.
In this study, we report a synthetic strategy to prepare a conjugate of a tricarbocyanine (heptamethine cyanine) dye with trehalose and evaluate its photodynamic effect against mycobacteria (slow-growing M. tuberculosis and fast-growing M. smegmatis) in different physiological states to demonstrate proof of principle.
3. Discussion
By selectively targeting specific molecules, light-active compounds have the ability to address limitations in drug discovery. Progress in synthesizing and testing photosensitizer conjugates with biomolecules like antibodies, peptides or small-molecule drugs is resulting in more effective agents for eliminating a wide range of microbial species [
24].
In the present study, we sought to combine the spectral advantages of TCC for deeper light penetration of tissues upon aPDT with trehalose conjugation (
Figure 1) for improved targeting of mycobacteria. To this end, to demonstrate proof of principle we synthesized novel trehalose conjugates of TCC (TCC2Tre) in the form of a mixture of six isomers, which are activated by light at a wavelength of 740 nm. The obtained isomers were formed because trehalose units bonded to TCC at a different carbon atoms with a predominant isomer of the sixth carbon atom in two trehalose units. We attempted to use OH-protected trehalose, more specifically, its hexa(trimethylsilyl) derivative with free hydroxyl groups at the sixth position. However, the trimethylsilyl groups were removed by cesium fluoride. The synthesis of pure TCC2Tre isomers requires the development of other synthetic strategies, which is currently underway. At same time, the trehalose mycolyltransesterase enzyme Ag85A, which transports trehalose into mycobacterial cells, revealed very broad substrate specificity processing equally well chemically modified trehalose (but not monosaccharides) [
19]. In interactome study, the lipoprotein LpqN was identified as a direct or indirect interacting partner of the mycolyltransferases FbpA and FbpB, as well as of the periplasmic domains of MmpL3 and MmpL11. LpqN also interacts with secreted cell envelope biosynthetic enzymes such as Ag85A via pulldown assays. The X-ray crystal structures of LpqN and LpqN bound to dodecyl-trehalose suggest that LpqN directly binds trehalose ester, the MmpL3 and Ag85A substrate. The crystal structures of LpqN in complex with trehalose-6-decanoate and dodecyl trehalose suggest that LpqN may directly bind different trehalose esters and thus serve as a facilitator of their periplasmic translocation [
25]. As a result, we might expect that all synthesized isomers are taken up by mycobacterial cells. Naturally, the synthesis and/or separation of individual active isomers and their study is necessary for their further application in pharmacology.
As expected, TCC2Tre demonstrated superior binding with
M. smegmatis cells in comparison with unconjugated TCC (
Figure 2). Correspondingly, the PDI of
M. smegmatis with TCC2Tre was more pronounced than that with TCC (
Figure 4 and
Figure 6a). The specificity of TCC2Tre for mycobacteria was evident from the comparison of its photoactivity against bacteria with different cell wall structures (
Figure 6). This was confirmed in the experiment with a mixed culture, where TCC2Tre was substantially more effective against
M. smegmatis than against
M. luteus (
Figure 7).
In two previous publications, the photoactivity of different PSs conjugated with trehalose towards mycobacteria was demonstrated. To improve the performance of photodynamic therapy for
M. smegmatis and
M. abscessus, PSs linked to trehalose (2AT2AT-PPIX; 6AT-I-BODIPY) were specifically designed. These compounds are able to penetrate the mycomembrane more effectively, resulting in a stronger photodynamic effect when exposed to light at a wavelength of 550–650 nm. These compounds exhibited minimal dark toxicity and were well tolerated by mammalian cells [
14]. In another study, a trehalose-porphyrin conjugate with a two-carbon linker (C2) was shown to display increased phototoxicity against
M. smegmatis following exposure to 415 nm light in comparison to the conjugate with a six-carbon linker (C6) [
26].
Trehalose conjugates of some fluorescent compounds were also used for the detection of
M. tuberculosis. Synthetic analogs of trehalose and trehalose monomycolate have demonstrated the ability to be incorporated into mycomembrane components in a specific and metabolically relevant manner. This enables their analysis in their natural environment and provides new opportunities for the targeted detection and treatment of mycobacterial pathogens within complex biological systems [
27,
28,
29,
30]. In particular, the fluorogenic dye DMN-Tre, a conjugate of 4-N,N-Dimethylamino-1,8-naphthalimide and trehalose, selectively labels the mycobacterial cell wall, making it a valuable tool for studying
M. tuberculosis physiology both in vitro and intracellularly [
31,
32]. A novel trehalose probe based on a 3-hydroxychromone (3HC-3) dye was developed. When attached to trehalose, this dye exhibits a 10-fold increase in fluorescence intensity compared to DMN-Tre [
33]. A fluorescent probe cephalosphorinase-dependent green trehalose (CDG-Tre) was constructed to specifically label single live Bacille Calmette-Guérin (BCG) cells within macrophages. CDG-Tre demonstrated high selectivity for mycobacteria compared to other species in the
Corynebacterineae suborder [
30]. Selective targeting of mycobacteria was also achieved using trehalose derivatized carbazole (Tre-Cz). The presence of trehalose in the conjugate with carbazole allowed for the detection of mycobacteria in mixed cultures and in patient sputum [
34]. Given that trehalose conjugates have the ability to reach the periplasmic space in mycobacteria, it is possible to design small molecules that can specifically bind to transmembrane protein domains for targeted immobilization. This strategy is not restricted to mycobacteria but can potentially be applied to various pathogens [
35].
In one of the aforementioned experiments, a trehalose conjugate with BODIPY was found to have a minimum inhibitory concentration of 0.5–33 µM for its photoactivity against
M. smegmatis and
M. abscessus according to the resazurin method for estimation of viability [
14]. However, for the trehalose-porphyrin conjugate, only one concentration of the compound was used (10 mM), which resulted in a discernible inhibition of
M. smegmatis growth according to the resazurin method [
26]. In our experiments, we determined the effect of PDI by counting cell viability via CFU, which directly estimates the bactericidal effect in contrast to the resazurin method. We found that 20 μM TCC2Tre was sufficient for photoinactivating 99.9% of mycobacteria (
Figure 4a). The discrepancy in the effective concentrations in the current work and previous publications may be attributed to different efficiency of PSs and the methodologies employed for phototoxicity and cell viability assessment.
TCC2Tre at a concentration of 40 µM produced significant killing effect on
M. tuberculosis cells (
Figure 10a). To the best of our knowledge, this represents the first instance of the application of a trehalose-conjugated PS for the PDI of the pathogenic
M. tuberculosis.
In the present study, the incubation periods of mycobacteria with the PSs were relatively short (2–3 h). It is evident that in mineral media such as PBS or Middlebrook base, in the absence of essential nutrients (e.g., glycerol, glucose, etc.), only a limited amount of TCC2Tre is capable of binding to the cell wall without being consumed by the cells during this period (
Figure 3b). At the same time, a significant increase in the quantity of bound TCC2Tre in the rich NB medium in comparison with the mineral media may be attributed to the uptake of the PS by cells within the first hour of incubation. Similarly, an increase in cell sensitivity to light during incubation with TCC2Tre but not TCC in the NB medium (
Figure 6a and
Figure 7b) may also reflect active uptake of TCC2Tre by cells. Active accumulation of trehalose-bound substances by mycobacterial cells and their incorporation in mycolic acids via a specific trehalose transporter over a 24 h incubation period was experimentally proven [
14,
31,
32,
33,
34].
The significantly lesser sensitivity of dormant
M. smegmatis cells for the PSs and the lesser difference in sensitivity between TCC2Tre and TCC could be due to the sufficiently depressed metabolism in dormant cells [
23] and suppression of transport processes. Nevertheless, the dormant cells still exhibited photosensitivity (
Figure 8), which could be due to the hydrophobic interaction of the dye molecules with the cell wall structure.
In conclusion, our work demonstrates the possibility of using PSs targeted to the cell wall of mycobacteria and activated in the near-infrared range, which expands the horizons for the aPDT of intracellular pathogens such as Mycobacterium tuberculosis. The application and study of the new PSs for in vivo PDT using laboratory animals are currently underway in our laboratory.
4. Materials and Methods
4.1. Bacterial Strains, Growth Media, and Culture Conditions
Strains Mycobacterium smegmatis mc2 155, Escherichia coli K-12 and Micrococcus luteus NCIMB 13267 (previously described as Fleming strain 2665) were grown aerobically in 20 mL of the peptide-rich nutrient broth (NB) medium (Himedia, Mumbai, India) for 20 h at 37 °C under constant shaking at 110 rpm. M. smegmatis were grown with Tween-80 (0.05%) added to the medium.
Strain Mycobacterium tuberculosis H37Rv was grown in Middlebrook 7H9 liquid medium (Himedia, India) with supplements (ADC and 0.05% Tween-80) for 7 days at 37 °C, under constant shaking at 180 rpm.
4.2. Synthesis of a Tricarbocyanine Dye Functionalized with Trehalose (TCC2Tre) and Its Characterization
TCC is a bromide salt of a hydrophobic 4-meso-chloro-substituted indotricarbocyanine dye with an indene moiety in the polymethine chain (
Figure 1). TCC was synthesized as described in Ref. [
10]. To obtain TCC2Tre, both carboxyl groups of TCC were esterified with trehalose (
Figure 1) using 1-methyl-2-bromo-1-methylpyridiniummethanesulfonate as an analogue of the Mukaiyama reagent [
20]. Anhydrous cesium fluoride (5 equiv.) and 1-methyl-2-bromo-1-methylpyridinium (2 equiv.) were added to a dimethylformamide solution of TCC. A dimethylformamide solution of anhydrous trehalose (4 equiv.) was then added to this mixture. After allowing the reaction mixture to stand at room temperature for 10 h, it was diluted with ethyl acetate, and the resulting precipitate was filtered through filter paper and washed with deionized water to remove cesium salts. After filtration, the precipitate was washed with acetone to remove TCC and pyridine compounds and then with ethanol.
The resulting compounds were characterized by high-performance liquid chromatography (HPLC) coupled to electrospray ionization mass spectrometry (ESI-MS). HPLC was performed on an Agilent 1200 LC system equipped with a Poroshell 120 EC-C18 column (4.6 × 50 mm, 2.7 µm). Mobile phase A was 0.05 vol% trifluoroacetic acid and mobile phase B was MeCN. The linear gradient was 40–95% phase B in 0–10 min. Chromatograms were recorded at 710 nm with a photodiode detector. After the chromatographic separation, absorption spectra were recorded using a diode-array detector. ESI-MS analysis was then performed on an Agilent 6410 Triple Quadrupole LC/MS system in positive ion detection mode with the fragmentor voltage set at 135 V.
The chromatogram for the synthesized compounds shows six peaks with retention times of 8.07, 8.19, 8.32, 8.45, 8.70 and 8.86 min (
Figure S1). The mass spectra for all these peaks contain species with
m/
z = 1309.5 corresponding to the esters of TCC with two trehalose units, i.e., TCC2Tre (
Figure S2). The additional peaks in the mass spectra with lower
m/
z values can be assigned to the fragments of the molecular ion of TCC2Tre that appear during electrospray ionization. The six species with
m/
z = 1309.5 correspond to esters formed between the carboxyl groups of TCC and various hydroxyl groups of trehalose. The primary hydroxyl group located at the sixth carbon atom (see
Figure 1) of trehalose is known to have the greatest relative reactivity [
36]. Therefore, the most intense HPLC peak with a retention time of 8.19 min should correspond to a diester bonded at the sixth carbon atom in both trehalose units. The HPLC peaks with retention times of 8.07 and 8.32 min are more intense compared to the rest of the peaks and can therefore be assigned to TCC esters with one of the trehalose units bonded at the sixth carbon atom and the other trehalose unit bonded at a different carbon atom. The absorption spectra corresponding to the six HPLC peaks are almost identical in position and shape (
Figure S3).
The chemical structure of TCC2Tre was also confirmed using
1H nuclear magnetic resonance (NMR) spectroscopy (
Figure S4). NMR spectra were as acquired in MeOD using an AVANCE 500 (Bruker) spectrometer at 25 °C and 500 MHz. The
1H NMR spectra for TCC2Tre, TCC and trehalose are shown in
Figure S4.
TCC2Tre: 1H NMR (500 MHz, MeOD) δ 8.45—8.01 (m, 4H), 7.67–6.98 (m, 12H), 5.56–4.99 (m, 8H), 4.45–3.40 (m, 16H), 2.75 (t, J = 36.7 Hz, 4H), 2.33–1.90 (m, 4H), 1.85–1.56 (m, 12H).
4.3. Binding of Tricarbocyanine Dyes with Mycobacterial Cells
An overnight culture of M. smegmatis was centrifuged (5 min at 8000 rpm), and the supernatant was discarded. The pellet was resuspended in PBS (50 mM, pH 7.45, Gibco, New York, NY, USA), the NB medium, or Middlebrook 7H9 mineral medium. The absorbance of the resulting cell suspensions at 590 nm was 0.2, which corresponded to ~107 cells/mL. M. smegmatis were incubated at 37 °C with different concentrations (5, 10, 20, 40 and 100 µM) of TCC2Tre and TCC. The dyes were introduced into cell suspensions via a DMSO solution, with the final concentration of DMSO in cell suspensions being 5 vol%. Following a 1, 2 or 3 h incubation period, the mycobacterial cells were washed with fresh PBS and centrifuged at 8000 rpm for 5 min three times. Following this, the cells were resuspended in PBS to a concentration of 107 cells/mL and transferred to 1 cm semi-micro polystyrene cuvettes (Fisher Scientific, Pittsburgh, PA, USA, catalog No. 11547692). Absorption spectra of the cell suspensions were acquired using a SOLAR PV1251 spectrophotometer.
4.4. Preparation of the Dormant Forms of M. smegmatis upon the Medium Self-Acidification
Mycobacterium smegmatis mc
2155 cells were initially grown in the NB medium at 37 °C for 24 h, with shaking at 200 rpm. The inoculum (1 mL) was added to 100 mL of Sauton medium, containing (g/L) K
2HPO
4, 0.5; MgSO
4·7H
2O, 1.4; L-Asparagine, 4.0; ferric ammonium citrate, 0.05; Na
3(citrate), 2.0; ZnSO
4, 0.001 (Sigma Aldrich, Burlington, VT, USA), and 0.2 vol% glycerol (Panreac, Barcelona, Spain). The initial pH value was 6.0 (instead of pH 7.0 typical of the usual Sauton composition). To prevent aggregation of the cells, Tween-80 was added (0.05%). The culture was grown at 37 °C under constant stirring (200 rpm) for 18 days until a constant pH value (ca. 6.0) of the medium was established [
23]. Dormant cells were stored for 6 months without agitation in 15 mL capped tubes in the dark.
4.5. Preparation of Bacteria for Photoinactivation
The bacterial cell cultures were diluted with sterile culture medium to the desired absorbance. The absorbance was measured in 1.5 mL plastic cuvettes with an optical path length of 10 mm using a photoelectric colorimeter (Biochrom WPA CO7500 Colourwave, Biochrom, Cambridge, UK). The culture medium was used as a control. One mL of cell suspension (0.1 absorbance at 590 nm) and 10 µL of a 4 mM TCC (or TCCTre) solution were added to a sterile 2 mL tube. Bacteria were incubated with the dyes for different time intervals at 37 °C under constant stirring. Following the incubation period, the cells were centrifuged for 10 min at 10,000 rpm. The precipitate was washed two times with PBS for 10 min at 10,000 rpm.
4.6. Antibacterial Photoinactivation
Suspensions of bacteria with 0.1 absorbance at 590 nm, which corresponds to ca. 10
7 bacteria per mL, were used for light inactivation experiments. Aliquots (100 µL) of the bacterial suspensions were placed in the wells of a 96-well plate (Nunc). Illumination was carried out using a 740 nm LED SOLIS-740C (Thorlabs, Newton, NJ, USA) with a bandwidth of 45 nm (full width at half maximum). The light beam was collimated to a diameter of 5 mm, corresponding to the diameter of the wells of a 96-well plate. Illumination coupling MT-CON with optimized optics for bright bottom homogenous illumination of a suspension in the wells was used. The irradiance in each mode of the LED was measured with a Newport 2936-c power meter (
Table 2). In most cases, a light dose of 468 J/cm
2 (240 mW/cm
2 irradiance and 30 min illumination time) was used. For some experiments, a light dose of 100 J/cm
2 was used, which was obtained with a different irradiance (
Table 2). The temperature in was controlled with a Fluke 80BK Type K Multimeter Thermocouple Temperature Probe (Fluke Corporation, Everett, Washington, DC, USA) directly in the microwells before and after illumination and in the presence and without dyed
M. smegmatis suspension with ±0.2 °C precision. The temperature was lower than 40 °C in the wells during all the experiments.
After illuminating the samples, serial tenfold dilutions (10−1 to 10−7) were prepared in the NB medium with 0.05% Tween-80, and aliquots (3 × 20 μL) were plated on NB agar plates for CFU (for vegetative bacteria) or MPN (for dormant bacteria) determination.
4.7. Viability Estimation by CFU
For M. smegmatis, E. coli, and M. luteus, bacterial suspensions were serially diluted in fresh NB medium, and then three replicate 10 μL samples from each dilution were spotted on NB (Himedia, India) agar. The plates were incubated at 37 °C for 3–5 days, then the number of colony forming units (CFUs) was counted.
For M. tuberculosis, bacterial suspensions were serially diluted in fresh 7H9 medium (Himedia, India) containing 0.05% Tween-80, and then three replicate 10 μL samples from each dilution were spotted on 7H10 (Himedia, India) agar. Plates were incubated at 37 °C for 21 days, and then the number of colony forming units (CFUs) was counted. The limit of detection was 10 CFU/mL.
4.8. MPN Assay
The MPN procedure was performed for dormant
M. smegmatis cells in 48-well plastic plates (Corning Inc., Corning, NY, USA) filled with a 1:1 mixture of Sauton medium and the NB medium. Appropriate serial dilutions of
M. smegmatis cells (100 μL) were added to each well. The plates were incubated at 37 °C with agitation (130 rpm) for 14 days. Wells with the visible bacterial growth were counted as positive, and the MPN values were calculated using standard statistical methods [
37,
38]. These experiments were performed two times in three technical replicas.
4.9. Statistics
Statistical processing was carried out via the analysis of the standard deviation or relative error within each data group. All the data are presented as the mean values of three replicate determinations. The MPN values were determined using de Man’s tables calculated on the basis of a Poisson distribution [
30]. For the MPN assay, (95%) confidence limits were calculated [
38]. The MPN values were considered statistically different if low and high confidence limits were not overlapping. Student’s test assuming unequal variance was performed for estimation of significance for comparative data.
p-values are indicated as follows: * =
p < 0.05, ** =
p < 0.01, *** =
p < 0.001.